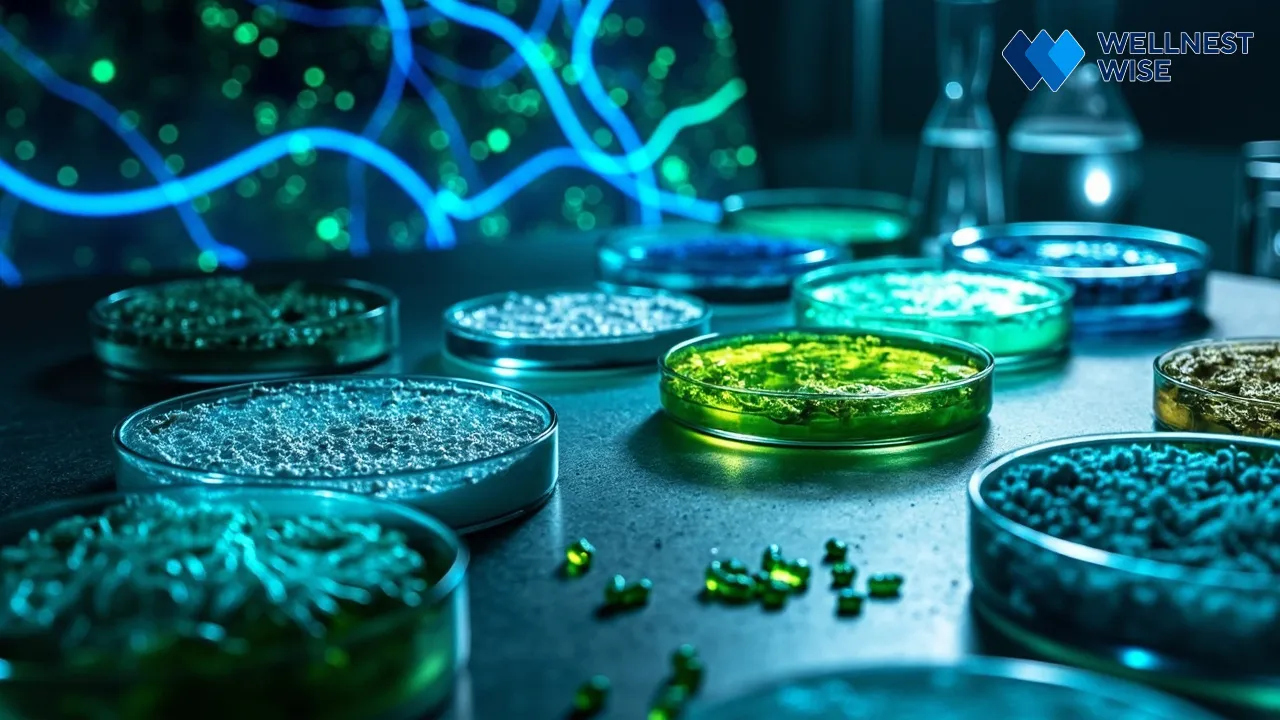
Scientific research on psychobiotics and future gut-brain discoveries.

Imagine a world where your mood isn’t solely dictated by your thoughts, but also by the bustling community of trillions of microbes living in your gut. For years, mental health care often overlooked the profound physical connections within our bodies. Yet, emerging science, coupled with real-world observations – like a friend’s journey through depression where targeted gut health interventions significantly complemented her therapy – increasingly reveals that our “second brain,” the gut microbiome, plays a pivotal role in our mental well-being. This intricate gut-brain connection offers a promising new lens through which to understand and address depression. Join us as we explore how these microscopic residents might be influencing your mind and what you can do about it.
Understanding the Intricate Gut-Brain Axis
It might sound like science fiction, but the idea of your gut “talking” to your brain is very real. This constant, intricate dialogue forms the foundation of what scientists call the gut-brain axis, a powerful bi-directional communication highway connecting your digestive system and your central nervous system. This isn’t just about feeling “butterflies in your stomach”; it’s a sophisticated network where your gut microbes are active participants, profoundly influencing your emotional landscape and cognitive function.

Unraveling the Bi-directional Communication: What is the Gut-Brain Axis?
The gut-brain axis is essentially a complex communication system linking your brain with your enteric nervous system (ENS), which is often dubbed the “second brain” and resides within your gut. This axis isn’t a one-way street; signals flow constantly between your brain and gut, affecting everything from digestion to emotional responses. Hormones, immune system components, and nerves are all part of this dynamic interplay, making the connection between mental health and gut health far more significant than previously understood.
The Critical Role of Your Microbiota: A Foundation for Mental Wellness
At the heart of the gut-brain axis is your microbiota – the diverse ecosystem of bacteria, viruses, fungi, and other microorganisms residing primarily in your large intestine. Far from being passive residents, these microbes are metabolic powerhouses. They break down food compounds our bodies can’t digest, produce essential vitamins, and, crucially, synthesize a wide array of neuroactive compounds. A healthy, diverse microbiota is now recognized as a fundamental component of mental wellness, influencing everything from stress resilience to mood regulation.
Key Communication Pathways: How Gut and Brain Interact
The conversation between your gut and brain occurs through several key pathways. These include the vagus nerve, a direct neural link; the endocrine system, involving hormones like cortisol (the stress hormone); the immune system, where gut-derived inflammatory signals can impact the brain; and the metabolic pathways, where microbial byproducts directly influence brain chemistry. Understanding these intricate interactions is key to appreciating the mental health gut link and its implications for conditions like depression.
How Gut Microbes Shape Brain Function and Mood
It’s astonishing to consider that the tiny organisms in your gut might be dictating how you feel. Yet, a growing body of scientific evidence reveals that gut microbes are not merely processing your food; they are actively involved in the production of vital compounds that directly impact your brain’s function and, consequently, your mood. From manufacturing neurotransmitters to taming inflammation, your microbial inhabitants wield considerable influence over your emotional state and cognitive health, opening new avenues for holistic depression treatment.

The Gut as a Neurotransmitter Factory: Serotonin, GABA, and Mood Regulation
Perhaps one of the most remarkable discoveries is the gut’s capacity to act as a neurotransmitter factory. Did you know that an estimated 90% of your body’s serotonin, a crucial neurotransmitter associated with feelings of well-being and happiness, is produced in the gut? [1] Certain gut bacteria are directly involved in the synthesis of serotonin, as well as other calming neurotransmitters like gamma-aminobutyric acid (GABA), which helps regulate anxiety. This means the composition and activity of your gut microbiome can profoundly affect the availability of these mood-regulating chemicals in your body, influencing mood regulation and potentially contributing to depressive symptoms when production is compromised.
Short-Chain Fatty Acids (SCFAs): Microbial Metabolites with Brain-Boosting Power
When beneficial gut bacteria ferment dietary fibers, they produce compounds known as short-chain fatty acids (SCFAs), primarily acetate, propionate, and butyrate. These SCFAs are not just energy sources for your gut cells; they are powerful signaling molecules that cross the gut barrier and circulate throughout your body, including your brain. Butyrate, for instance, has been shown to support brain health by strengthening the gut barrier, reducing inflammation, and potentially influencing gene expression in brain cells. These microbial metabolites offer a tangible link between the food you eat, your gut health, and your cognitive and emotional well-being.
Taming Inflammation: How Gut Health Impacts Brain Inflammation and Mental Illness
Chronic, low-grade inflammation is increasingly recognized as a significant factor in the development and persistence of mental illness, including depression. A healthy gut microbiome plays a vital role in maintaining the integrity of the gut lining, preventing harmful substances and bacteria from “leaking” into the bloodstream (a condition known as “leaky gut”). When the gut barrier is compromised or the microbiome is imbalanced, it can trigger systemic inflammation. This inflammation can then extend to the brain, disrupting neurotransmitter function, altering brain circuitry, and contributing to the symptoms of depression. Conversely, a balanced gut can help to reduce systemic inflammation, potentially alleviating brain inflammation and improving mental health outcomes [1].
The Vagus Nerve: Direct Highway Between Your Enteric and Central Nervous Systems
The vagus nerve is the longest cranial nerve, acting as a superhighway of communication, sending signals directly between the brain and nearly all major organs, including the gut. This nerve allows for incredibly rapid, direct communication along the gut-brain axis. Research indicates that microbial metabolites and even specific bacterial strains can influence the vagus nerve’s activity, which in turn impacts mood, stress responses, and overall brain function. A healthy, balanced microbiome can enhance vagal tone, leading to improved stress resilience and better emotional regulation.
When the Gut Microbiome is Out of Balance: Dysbiosis and Depressive Symptoms
Just as a thriving garden brings joy, an imbalanced one can lead to distress. When the delicate ecosystem of your gut microbiome falls out of harmony, a condition known as dysbiosis occurs. This imbalance isn’t just a digestive nuisance; it can have profound implications for your mood and overall mental health, potentially exacerbating or even contributing to depressive symptoms. Understanding dysbiosis is critical to grasping the full scope of the mental health gut link.

Defining Gut Dysbiosis: An Imbalance in Your Inner Ecosystem
Gut dysbiosis refers to an altered composition or function of the gut microbiome, where there’s an unhealthy shift in the balance of beneficial versus harmful bacteria. This can manifest as a lack of diversity in microbial species, a reduction in beneficial strains (like Lactobacillus and Bifidobacterium), or an overgrowth of pathogenic bacteria or yeasts. This imbalance can impair gut barrier function, increase inflammation, and disrupt the production of key microbial metabolites, all of which can ripple through the gut-brain axis.
The Link to Depression: How Dysbiosis May Exacerbate Mental Health Challenges
Mounting evidence suggests a strong correlation between gut dysbiosis and depressive symptoms. Studies have shown that people experiencing depression often exhibit significant differences in their gut microbiota composition compared to healthy individuals, including reduced diversity and lower levels of beneficial bacteria [1]. This altered microbial profile can lead to decreased serotonin production in the gut, increased systemic inflammation, and a compromised gut barrier, all factors known to contribute to the pathophysiology of depression. While dysbiosis isn’t the sole cause of depression, it’s increasingly recognized as a significant contributing or exacerbating factor, highlighting the importance of gut health in mental health gut link.
“During my graduate studies in nutrition, I encountered a case where a close friend struggled with depression resistant to conventional treatment. After extensive research and consultation, we introduced dietary changes focused on enhancing gut health, such as increasing fermented foods and fiber intake alongside probiotics with strains shown to influence neurotransmitter production. Over months, I noticed subjective improvements in her mood stability and energy, which her therapist also confirmed objectively. This experience deeply highlighted the gut-brain axis potential and motivated my interest in microbiome research related to mental health. It was a hopeful reminder that nutrition and microbial health could be complementary tools in managing complex disorders like depression.”
Common Factors Contributing to Microbiome Imbalance
Several everyday factors can disrupt the delicate balance of your gut microbiome, paving the way for dysbiosis:
Dietary Habits and Ultra-Processed Foods
A diet high in ultra-processed foods, refined sugars, unhealthy fats, and artificial additives provides poor fuel for beneficial gut bacteria, while encouraging the growth of less desirable species. Lack of dietary fiber, a primary food source for beneficial microbes, further starves the healthy community, leading to a less diverse and less resilient microbiome.
Stress, Sleep Disturbances, and Antibiotic Use
Chronic stress can directly alter gut permeability and microbial composition. Similarly, inadequate or disturbed sleep can negatively impact gut diversity. Perhaps one of the most potent disruptors is the use of antibiotics, which, while vital for fighting infections, can decimate both harmful and beneficial bacteria, leading to prolonged microbial imbalance.
Empowering Your Gut: Nutritional Strategies for a Healthier Microbiome and Improved Mood
The good news is that you have significant power to positively influence your gut microbiome through your daily choices, especially what you eat. Adopting a gut-friendly diet isn’t just about digestion; it’s a proactive step towards a healthier mind and an improved mood. By focusing on nourishing your beneficial bacteria, you can foster a more resilient inner ecosystem that supports optimal brain function and emotional well-being, acting as a vital component of a holistic depression treatment approach.

Nourishing Your Beneficial Bacteria: The Power of Prebiotics
Prebiotics are specialized plant fibers that selectively feed the beneficial bacteria in your gut. Think of them as fertilizer for your inner garden. By increasing your intake of prebiotic-rich foods, you help these friendly microbes thrive, boosting their numbers and their ability to produce beneficial compounds like short-chain fatty acids (SCFAs) that impact the brain.
- Inulin-rich foods: Chicory root, Jerusalem artichokes, garlic, onions, leeks, asparagus.
- Fructooligosaccharides (FOS): Bananas, onions, garlic, barley, rye, some fruits.
- Resistant starch: Green bananas, cooked and cooled potatoes/rice, oats, legumes.
- Pectin: Apples, citrus fruits, berries.
Introducing Friendly Microbes: Understanding Probiotics for Depression
Probiotics are live beneficial bacteria that, when consumed in adequate amounts, confer a health benefit to the host. For individuals seeking to support their mental well-being, specific probiotic strains, sometimes termed “psychobiotics,” are garnering significant interest for their potential influence on the gut-brain axis and mood regulation.
- Specific Probiotic Strains and Their Potential Impact: Research into probiotics for depression is expanding, with certain Lactobacillus and Bifidobacterium species showing promise in influencing neurotransmitter pathways and reducing inflammation. For example, some studies suggest that strains like Lactobacillus helveticus R0052 and Bifidobacterium longum R0175 may help alleviate anxiety and depressive symptoms [2].
- Food Sources: Incorporating naturally fermented foods into your diet is an excellent way to introduce beneficial microbes. These include unsweetened yogurt, kefir, sauerkraut (unpasteurized), kimchi, tempeh, and miso.
- Considerations for Supplementation: While food sources are great, probiotic supplementation can deliver higher, more targeted doses. When considering supplements, emphasize the importance of strain specificity (looking for strains identified in research related to mood), proper dosage, and always consulting a healthcare professional or registered dietitian before starting supplementation, especially if you have underlying health conditions or are taking medication.
| Probiotic Strain/Genus | Potential Benefit for Mood/Brain | Common Food Sources/Notes |
|---|---|---|
| :—————————– | :—————————————————————— | :——————————————————————————————— |
| Lactobacillus helveticus | May reduce anxiety, stress, and improve mood in some individuals. | Often found in fermented dairy products; specific strains in supplements. |
| Bifidobacterium longum | Linked to reduced anxiety, improved cognition, and stress response. | Present in some yogurts, fermented vegetables; specific strains in supplements. |
| Lactobacillus plantarum | Shown to improve mood, reduce stress, and enhance neurotransmitter function. | Fermented foods like sauerkraut, kimchi, sourdough; widely available in supplements. |
| Lactobacillus rhamnosus | May influence GABA receptors, potentially reducing anxiety. | Dairy products, some fermented foods; specific strains (e.g., GG) common in supplements. |
| Saccharomyces boulardii | Non-bacterial yeast, supports gut barrier, reduces inflammation. | Found in some specialty yogurts, kefir; often used in travel/antibiotic-associated diarrhea. |
The Mediterranean Diet and Other Gut-Friendly Eating Patterns: A Holistic Approach
Beyond focusing on individual foods, adopting broader, gut-friendly eating patterns can have a profound impact. The Mediterranean diet, rich in whole grains, fruits, vegetables, legumes, nuts, olive oil, and lean proteins, is a prime example. This dietary pattern naturally provides an abundance of fiber and diverse micronutrients that support a healthy microbiome, while reducing inflammatory foods. Such a holistic approach aligns perfectly with the principles of nourishing both your body and mind for improved mood.
Limiting Gut Disruptors: Reducing Processed Foods and Artificial Sweeteners
Just as important as adding beneficial foods is reducing those that harm your gut. Processed foods, high in refined sugars, unhealthy fats, and artificial ingredients, can fuel undesirable bacteria and contribute to gut inflammation. Similarly, certain artificial sweeteners have been shown to negatively impact gut microbial composition. Consciously limiting these gut disruptors is a crucial step in maintaining a healthy, balanced microbiome that supports mental well-being.
Beyond Diet: Lifestyle Modulators for the Gut-Brain Axis
While nutrition plays a colossal role, our emotional state and physical habits are equally influential in shaping the intricate gut-brain axis. It’s a holistic dance where diet, stress, sleep, and physical activity all contribute to the overall harmony or discord within your inner ecosystem. Embracing a comprehensive approach to lifestyle can significantly impact your microbiota and mood, offering further avenues for strengthening the mental health gut link.

Managing Chronic Stress: Impact on the Microbiome and Mental Health
Chronic stress doesn’t just affect your mind; it directly impacts your gut. Stress hormones can alter the composition of your gut microbiome, increase gut permeability (“leaky gut”), and influence the speed of digestion. This can lead to dysbiosis and inflammation, further exacerbating the stress response in a vicious cycle. Implementing effective stress management techniques like mindfulness, deep breathing, or spending time in nature can help buffer these negative effects, promoting a more balanced gut and a calmer mind.
The Restorative Power of Sleep: A Gut-Brain Connection
Quality sleep is foundational for both physical and mental health, and its connection to the gut-brain axis is undeniable. Irregular sleep patterns or chronic sleep deprivation can disrupt circadian rhythms, which in turn affect the daily rhythms of your gut microbes. This disruption can lead to imbalances in the microbiome, potentially increasing inflammation and negatively impacting mood. Prioritizing consistent, restorative sleep is a powerful way to support both your gut health and your mental well-being.
Physical Activity: Movement for a Healthier Gut and Happier Mind
Regular physical activity is a well-known mood booster, and emerging research suggests it also positively influences the gut microbiome. Exercise can increase the diversity of beneficial gut bacteria and enhance the production of short-chain fatty acids (SCFAs), which have anti-inflammatory and brain-protective effects. Whether it’s a brisk walk, yoga, or a more intense workout, moving your body can contribute to a healthier gut and, consequently, a happier mind.
Mind-Body Practices: Cultivating Resilience for Both Gut and Brain
Techniques that integrate the mind and body, such as meditation, yoga, or tai chi, are not just for relaxation; they actively strengthen the gut-brain axis. These practices can reduce stress hormones, improve vagal tone, and positively influence the immune system, all of which contribute to a more balanced microbiome. By cultivating mental resilience, you are simultaneously nurturing a healthier environment within your gut, fostering a harmonious connection between your inner and outer worlds.
The Evolving Science: Psychobiotics and Future Directions in Depression Research
The intersection of gut health and mental well-being is a rapidly advancing field, with psychobiotics emerging as a particularly exciting area. These novel therapies aim to directly target the microbiota-gut-brain axis to improve mental health. While the science is still evolving, the potential for personalized, microbiome-based interventions offers a beacon of hope for future depression research and treatment, adding a new dimension to our understanding of the gut microbiome and depression.
What Are Psychobiotics? Emerging Therapies Targeting the Microbiota-Gut-Brain Axis
Psychobiotics are a class of probiotics that, when ingested in adequate amounts, produce a mental health benefit by modulating the microbiota-gut-brain axis. Unlike general probiotics, psychobiotics are specifically chosen or developed for their neuroactive properties, such as their ability to produce neurotransmitters (like GABA or serotonin precursors), reduce inflammation, or modulate the stress response. These emerging therapies represent a targeted approach to address the mental health gut link.
Current Research and Promising Findings: A Look at the Evidence
Initial research into psychobiotics benefits has yielded promising, albeit preliminary, findings. Some randomized controlled trials have shown that specific probiotic supplementation can lead to modest improvements in symptoms of anxiety and depression in certain populations [1, 2]. For example, studies using mixtures of Lactobacillus and Bifidobacterium strains have observed positive effects on mood and cognitive function. This exciting area of diet and depression research is continuously uncovering more about how specific microbial interventions can influence our mental state.
Limitations and Future Perspectives: Navigating the Complexities of Individual Responses
Despite promising results, the field of psychobiotics and the gut-brain axis is still young. One major limitation is the wide variability in individual responses to interventions, underscoring the unique nature of each person’s microbiome. Factors like diet, genetics, lifestyle, and existing medical conditions all play a role in how effectively a psychobiotic might work. Future depression research needs larger, more diverse human studies to pinpoint optimal strains, dosages, and treatment durations. The ultimate goal is to develop personalized, microbiome-based therapies that precisely target individual needs, offering new hope for those struggling with depression.
Important Considerations: When to Consult a Healthcare Professional
While embracing gut health strategies can be incredibly empowering, it’s crucial to remember that they are complementary approaches, not replacements for professional medical and mental health care. The journey to improved mental well-being can be complex, and expert guidance is essential to ensure a safe, effective, and personalized path. Understanding when to seek professional help is a cornerstone of responsible and holistic health management.

The Complementary Role of Gut Health Strategies in Depression Management
Strategies aimed at nurturing your gut microbiome, such as dietary changes and probiotics for depression, can be powerful allies in supporting your mental health. They can work in conjunction with conventional treatments like therapy and medication, potentially enhancing their effectiveness and contributing to overall well-being. Think of them as additional tools in your mental health toolkit, helping to build a stronger foundation from within.
Recognizing When Professional Medical and Mental Health Guidance is Essential
It’s vital to recognize that serious mental health conditions, including clinical depression, require professional diagnosis and treatment. If you are experiencing persistent feelings of sadness, hopelessness, loss of interest, significant changes in appetite or sleep, or thoughts of self-harm, please seek immediate help from a qualified healthcare provider. Gut health strategies should never delay or replace necessary medical or psychological interventions. Your doctor or therapist can assess your situation comprehensively and guide you toward appropriate care.
Personalized Approaches: Working with Dietitians and Doctors for Optimal Outcomes
Because each individual’s gut microbiome is unique, a “one-size-fits-all” approach rarely yields the best results. For optimal outcomes, consider working with a healthcare professional, such as a doctor, psychiatrist, or a registered dietitian specializing in gut health and mental wellness. They can help you develop a personalized approach that considers your specific health profile, dietary needs, and mental health challenges. This collaborative effort ensures that your gut health strategies are tailored to you, maximizing their potential to support your journey to improved mood and overall well-being.
Nurturing Your Inner Ecosystem for Enhanced Mental Well-being
The profound connection between your gut and your mind is an undeniable reality, a testament to the intricate wonders of the human body. As we’ve explored the fascinating world of the gut-brain axis, the impact of your microbiome on depression, and the potential for a holistic depression treatment approach, it’s clear that nurturing your inner ecosystem is a powerful step towards enhanced mental well-being. Your gut isn’t just about digestion; it’s a vital partner in your emotional and cognitive health.

Key Takeaways: The Profound Connection Between Your Gut and Your Mind
The journey through the gut-brain connection reveals several crucial insights: your gut microbiome actively influences brain chemistry and function, impacting your mood through neurotransmitter production, inflammation modulation, and the vagus nerve. An imbalance in this delicate ecosystem, known as dysbiosis, can exacerbate depressive symptoms. Crucially, through intentional dietary choices rich in prebiotics and beneficial probiotics for depression, alongside mindful lifestyle practices like stress management and quality sleep, you possess significant power to cultivate a healthier gut and, in turn, a more resilient mind.
A Path Forward: Embracing an Integrated Approach to Mood and Microbiome Health
Embracing an integrated approach to mood and microbiome health isn’t just a trend; it’s a scientifically supported pathway to potentially improving your mental well-being. It means understanding that your gut health is an integral, complementary component of your overall mental health strategy. By making conscious choices to nourish your inner ecosystem, manage stress, prioritize sleep, and engage in physical activity, you are actively participating in a continuous dialogue between your gut and your brain, fostering harmony and resilience. Remember to always consult with healthcare professionals for personalized guidance, ensuring that your journey towards a happier mind is both informed and supported.
FAQ
How does the gut microbiome communicate with the brain?
The gut microbiome communicates with the brain through a complex bi-directional network called the gut-brain axis. This communication occurs via several pathways: the vagus nerve (a direct neural link), the endocrine system (hormone signaling), the immune system (inflammatory responses), and the metabolic pathways (microbial byproducts like short-chain fatty acids and neurotransmitters). These interactions allow gut microbes to influence brain function, mood, and behavior.
Can dietary changes or probiotics alleviate depressive symptoms?
While not a standalone cure, dietary changes and probiotic supplementation can play a significant complementary role in managing depressive symptoms. A diet rich in fiber, fermented foods, and whole, unprocessed ingredients nourishes beneficial gut bacteria, leading to the production of mood-regulating compounds and reduced inflammation. Specific probiotic strains, often called psychobiotics, have shown modest improvements in mood and anxiety in some studies, but individual responses vary, and they should always be used under professional guidance alongside conventional treatments.
What are the latest scientific findings on the gut-brain link to depression?
Recent scientific findings on the gut-brain link to depression highlight the role of gut dysbiosis (microbial imbalance) in contributing to and exacerbating depressive symptoms. Research shows that individuals with depression often have altered gut microbiota composition, reduced microbial diversity, and increased systemic inflammation linked to gut health. Emerging studies on psychobiotics are identifying specific bacterial strains that can modulate neurotransmitter production, reduce stress, and improve mood. While promising, researchers emphasize the need for more large-scale human trials to develop personalized, evidence-based microbiome-targeted therapies for depression research.
